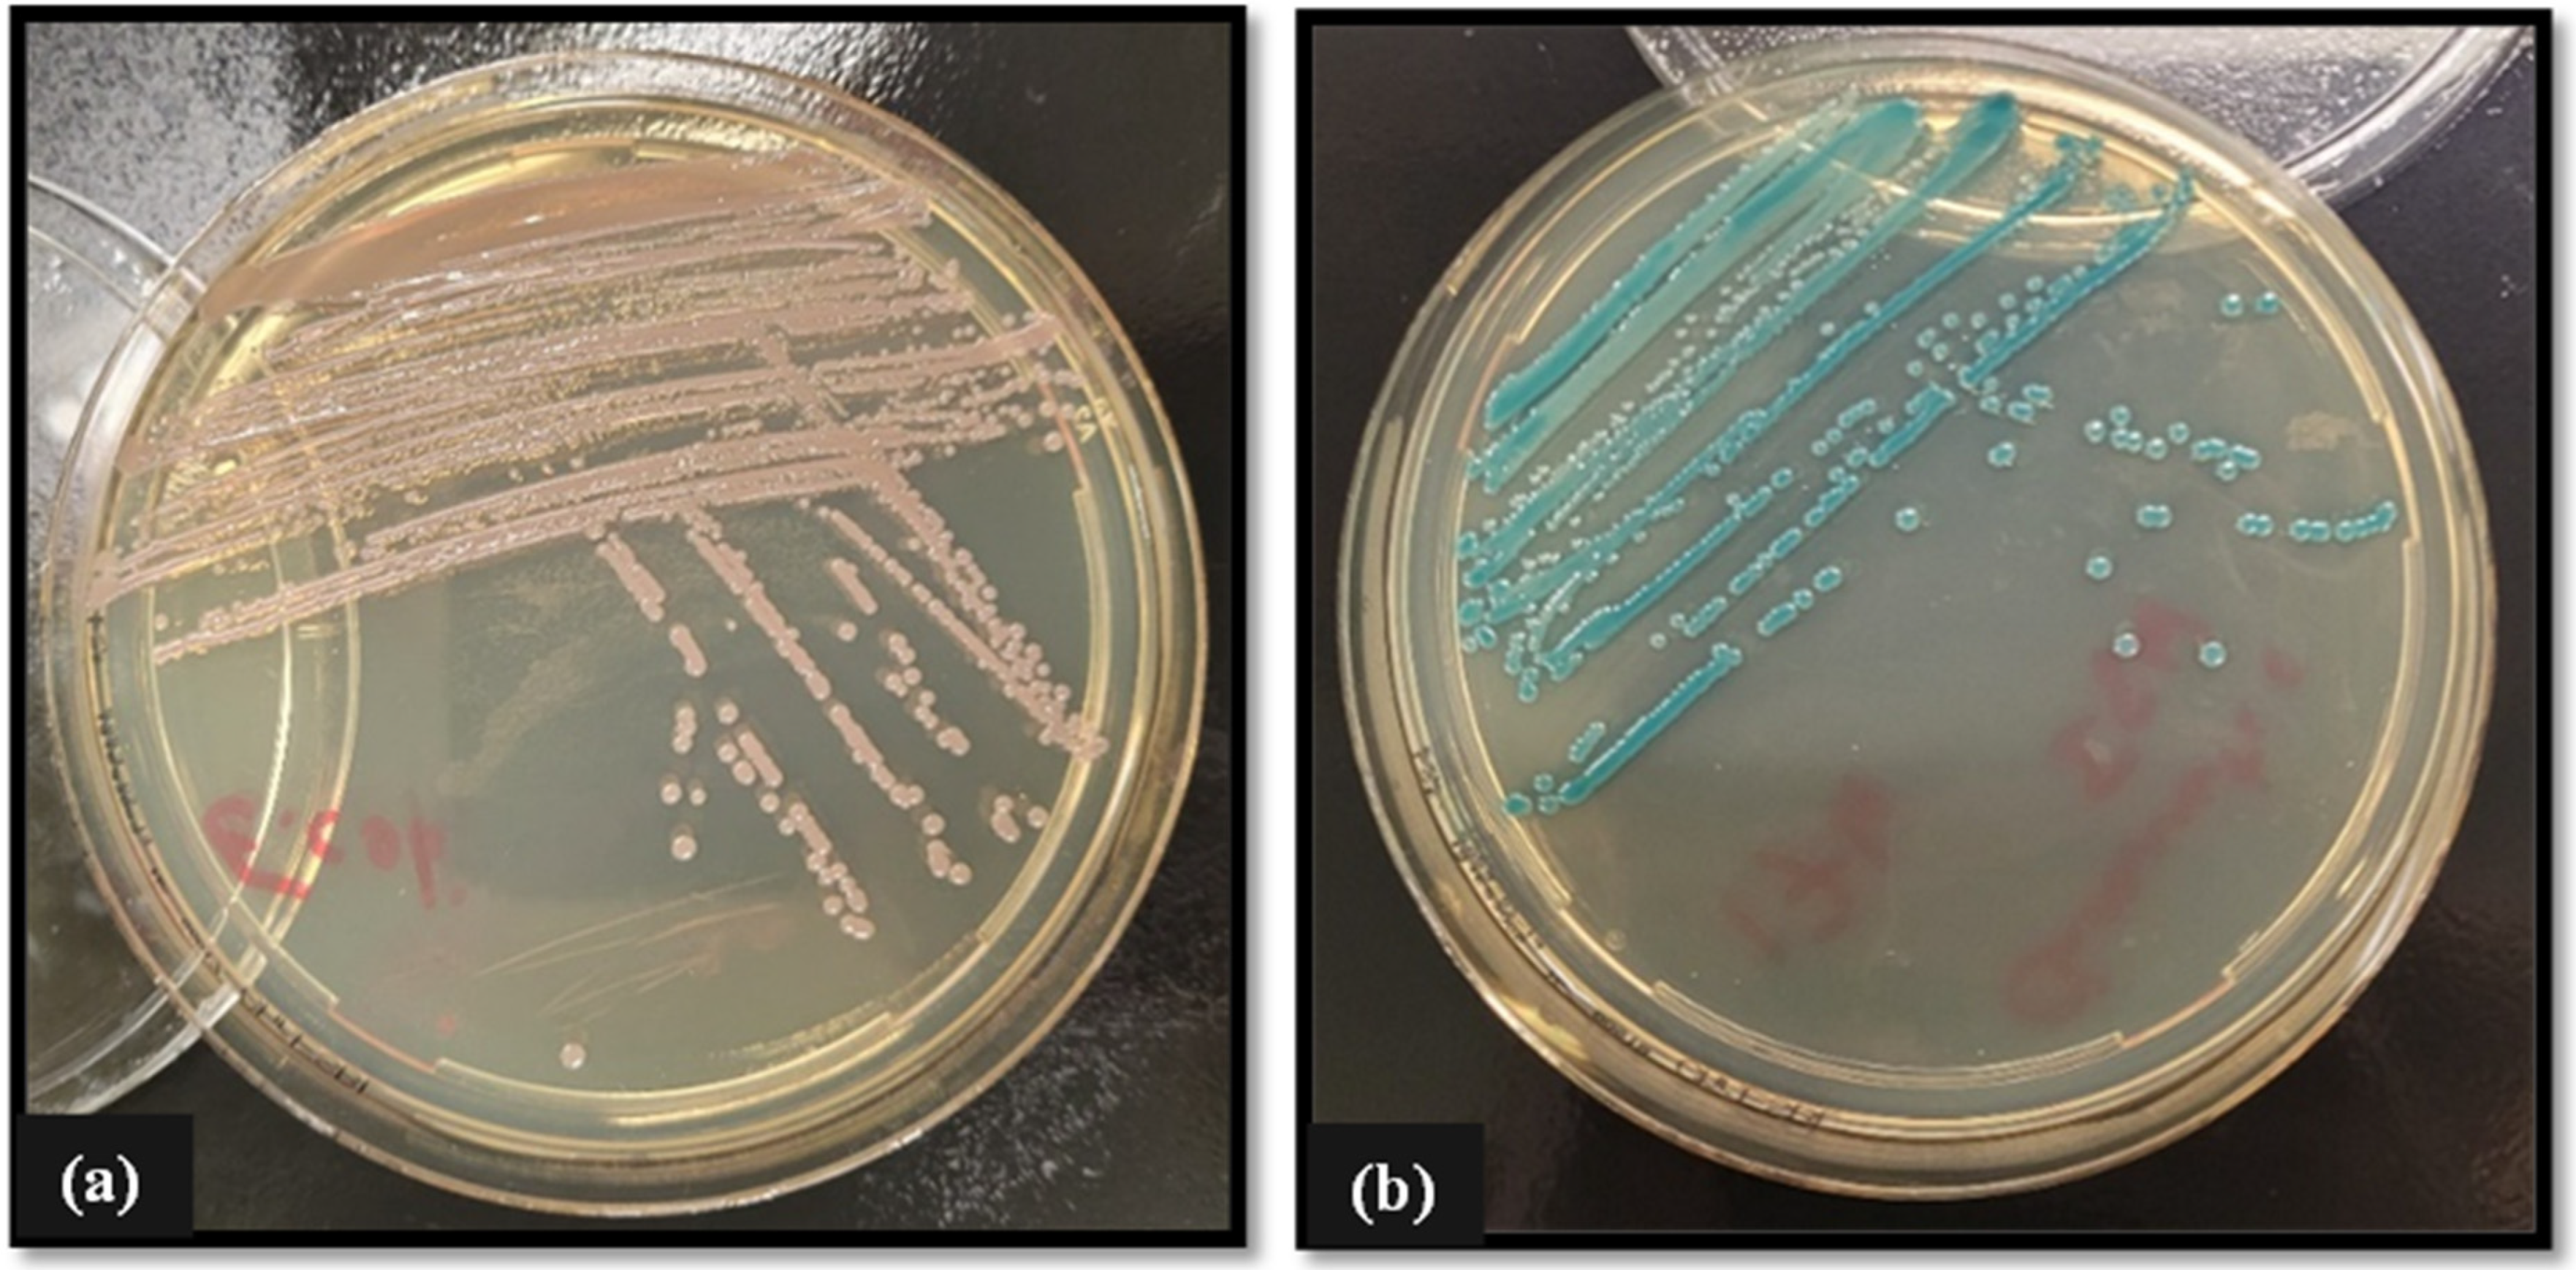
Pathogens 13 01006 g002
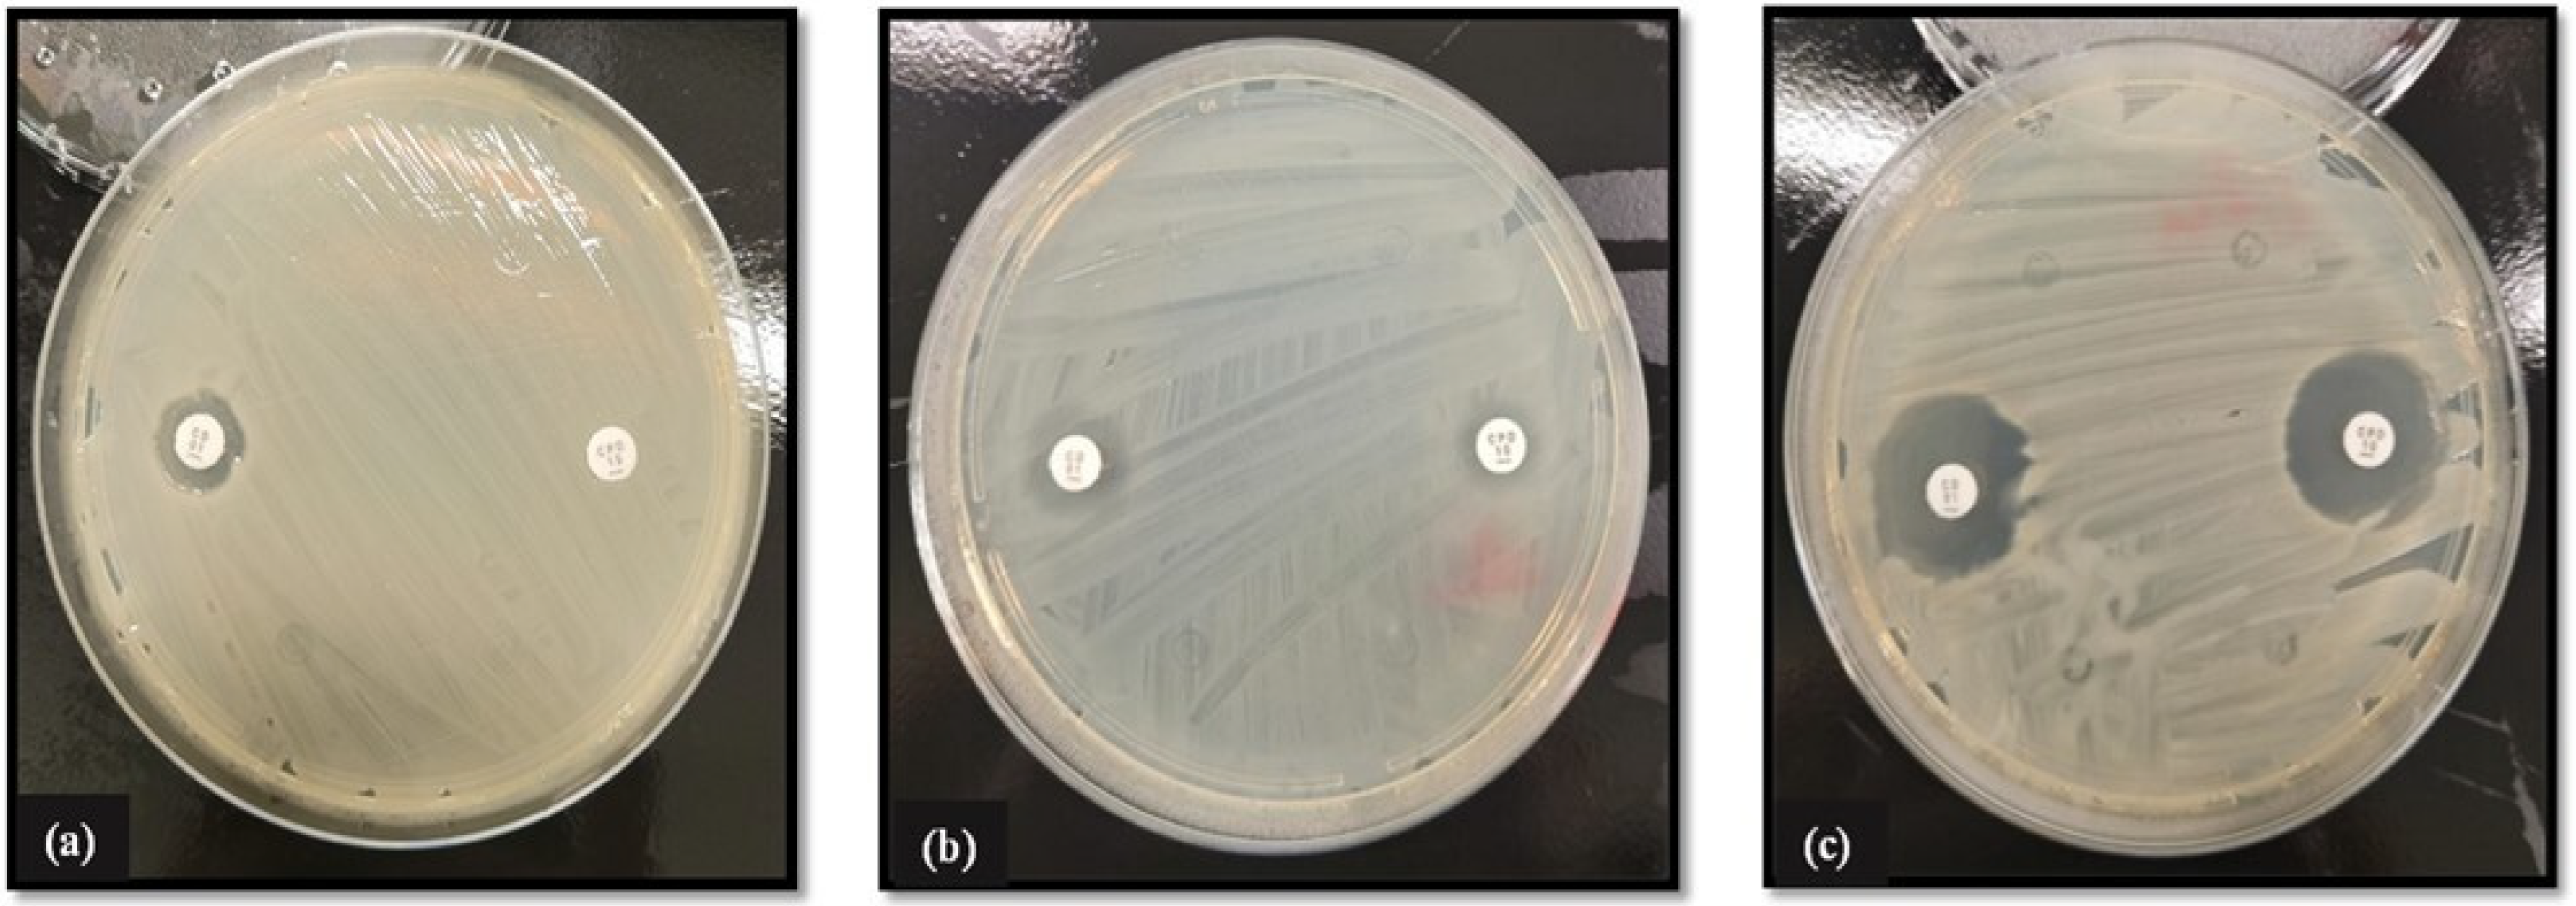
Pathogens 13 01006 g003
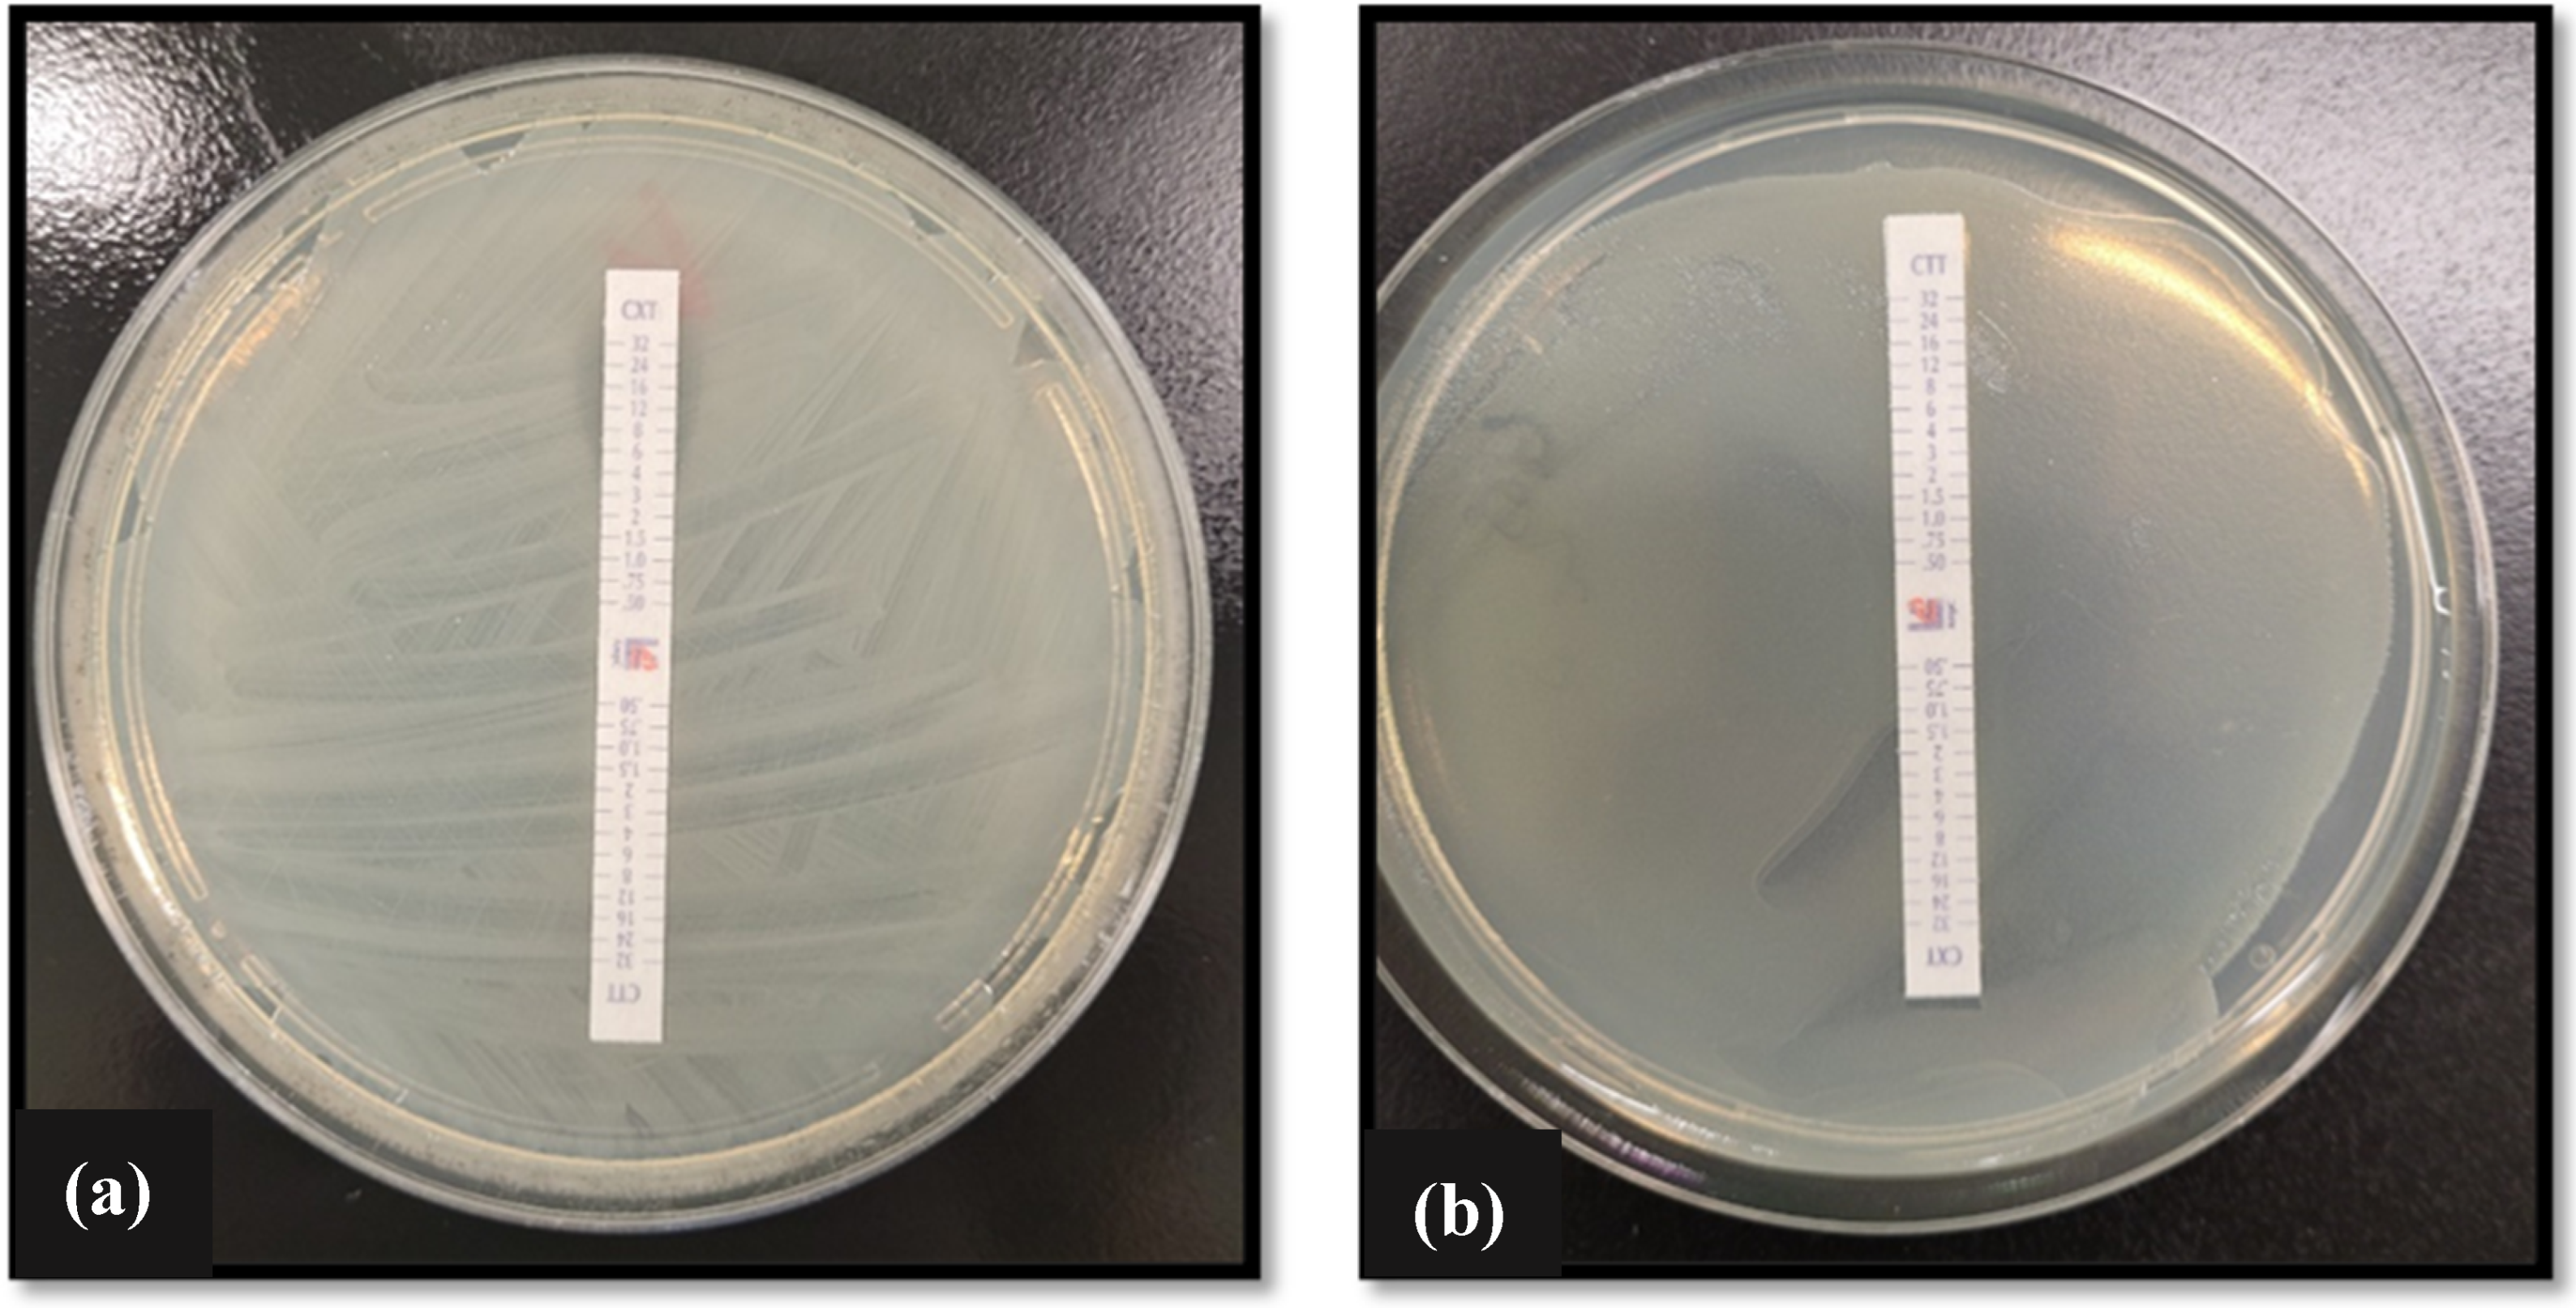
Pathogens 13 01006 g004

Antimicrobial Resistance Profile of Zoonotic Clinically Relevant WHO Priority Pathogens
Abstract
1. Introduction
2. Materials and Methods
2.1. Animal Morbidity Relating to Infection
2.2. Diagnostic Microbial Isolation, Identification, Culture, and Maintenance
2.3. PCR Identification
2.4. Antimicrobial Resistance Profile of Zoonotic Isolates
2.4.1. Disk Diffusion Assay
2.4.2. MIC-Gradient Test Strip Assay
2.5. Phenotypic Detection of ESBL and AmpC-Producing Bacterial Isolates
2.6. Genotypic Detection of ESBL and AmpC-Producing Isolates
3. Results
3.1. Characterization of β-Lactamase and AmpC Genes in Gram-Negative Isolates
3.2. Antimicrobial Susceptibility Profile of Isolated Bacterial Zoonotic Pathogens
3.3. Antimicrobial-Susceptibility Profile of Isolated Fungal Zoonotic Pathogens
4. Discussion
5. Conclusions
Author Contributions
Funding
Institutional Review Board Statement
Informed Consent Statement
Data Availability Statement
Conflicts of Interest
References
- WHO Fungal Priority Pathogens List to Guide Research, Development and Public Health Action. Available online: https://www.who.int/publications/i/item/9789240060241 (accessed on 26 June 2024).
- Meade, E.; Slattery, M.A.; Garvey, M. Biocidal Resistance in Clinically Relevant Microbial Species: A Major Public Health Risk. Pathogens 2021, 10, 598. [Google Scholar] [CrossRef] [PubMed]
- Santaniello, A.; Sansone, M.; Fioretti, A.; Menna, L.F. Systematic Review and Meta-Analysis of the Occurrence of ESKAPE Bacteria Group in Dogs, and the Related Zoonotic Risk in Animal-Assisted Therapy, and in Animal-Assisted Activity in the Health Context. Int. J. Environ. Res. Public Health 2020, 17, 3278. [Google Scholar] [CrossRef] [PubMed]
- Hindy, J.R.; Quintero-Martinez, J.A.; Lee, A.T.; Scott, C.G.; Gerberi, D.J.; Mahmood, M.; DeSimone, D.C.; Baddour, L.M. Incidence Trends and Epidemiology of Staphylococcus aureus Bacteremia: A Systematic Review of Population-Based Studies. Cureus 2022, 14, e25460. [Google Scholar] [CrossRef] [PubMed] [PubMed Central]
- Rahman, M.T.; Sobur, M.A.; Islam, M.S.; Ievy, S.; Hossain, M.J.; El Zowalaty, M.E.; Rahman, A.T.; Ashour, H.M. Zoonotic Diseases: Etiology, Impact, and Control. Microorganisms 2020, 8, 1405. [Google Scholar] [CrossRef] [PubMed] [PubMed Central]
- Sebola, D.C.; Oguttu, J.W.; Kock, M.M.; Qekwana, D.N. Hospital-acquired and zoonotic bacteria from a veterinary hospital and their associated antimicrobial-susceptibility profiles: A systematic review. Front. Vet. Sci. 2023, 9, 1087052. [Google Scholar] [CrossRef]
- Teixeira, M.; Pillay, S.; Urhan, A.; Abeel, T. SHIP: Identifying Antimicrobial Resistance Gene Transfer Between Plasmids. Bioinformatics 2023, 39, btad612. [Google Scholar] [CrossRef]
- De Oliveira, D.M.P.; Forde, B.M.; Kidd, T.J.; Harris, P.N.A.; Schembri, M.A.; Beatson, S.A.; Walker, M.J. Antimicrobial Resistance in ESKAPE Pathogens. Clin. Microbiol. Rev. 2020, 33, 10–128. [Google Scholar] [CrossRef]
- Westphal, G.A.; Pereira, A.B.; Fachin, S.M.; Barreto, A.C.C.; Bornschein, A.C.G.J.; Caldeira, F.M.; Koenig, Á. Characteristics and outcomes of patients with community-acquired and hospital-acquired sepsis. Rev. Bras. Ter. Intensiva. 2019, 31, 71–78. [Google Scholar] [CrossRef]
- Eucast: Clinical Breakpoints and Dosing of Antibiotics. Available online: https://www.eucast.org/clinical_breakpoints (accessed on 24 August 2024).
- Meade, E.; Savage, M.; Slattery, M.A.; Garvey, M. Disinfection of Mycotic Species Isolated from Cases of Bovine Mastitis Showing Antifungal Resistance. Cohesive J. Microbiol. Infect Dis. 2020, 3, CJMI.000571.2020. [Google Scholar] [CrossRef]
- Meade, E.; Savage, M.; Garvey, M. Effective Antimicrobial Solutions for Eradicating Multi-Resistant and β-Lactamase-Producing Nosocomial Gram-Negative Pathogens. Antibiotics 2021, 10, 1283. [Google Scholar] [CrossRef]
- Juliana, A.; Leela, K.V.; Gopinathan, A.; Sujith, R. Occurrence and Resistance Pattern of Gram-Negative Bacteremia and Sepsis in A Tertiary Care Hospital-A Four-Year Study. J. Pure Appl. Microbiol. 2022, 16, 655–662. [Google Scholar] [CrossRef]
- Castanheira, M.; Kimbrough, J.H.; DeVries, S.; Mendes, R.E.; Sader, H.S. Trends of β-Lactamase Occurrence Among Escherichia coli and Klebsiella pneumoniae in United States Hospitals During a 5-Year Period and Activity of Antimicrobial Agents Against Isolates Stratified by β-Lactamase Type. In Open Forum Infectious Diseases; Oxford University Press: Oxford, UK, 2023; Volume 10, p. ofad038. [Google Scholar] [CrossRef]
- Tamma, P.D.; Aitken, S.L.; Bonomo, R.A.; Mathers, A.J.; van Duin, D.; Clancy, C.J. Infectious Diseases Society of America 2022 Guidance on the Treatment of Extended-Spectrum β-lactamase Producing Enterobacterales (ESBL-E), Carbapenem-Resistant Enterobacterales (CRE), and Pseudomonas aeruginosa with Difficult-to-Treat Resistance (DTR-P. aeruginosa). Clin. Infect. Dis. 2022, 75, 187–212. [Google Scholar] [CrossRef] [PubMed] [PubMed Central]
- Mukherjee, S.; Mitra, S.; Dutta, S.; Basu, S. Neonatal Sepsis: The Impact of Carbapenem-Resistant and Hypervirulent Klebsiella pneumoniae. Front. Med. 2021, 8, 634349. [Google Scholar] [CrossRef] [PubMed]
- Jansen, S.J.; Lopriore, E.; van der Beek, M.T.; Veldkamp, K.E.; Steggerda, S.J.; Bekker, V. The road to zero nosocomial infections in neonates-a narrative review. Acta Paediatr. 2021, 110, 2326–2335. [Google Scholar] [CrossRef] [PubMed] [PubMed Central]
- Mattioni Marchetti, V.; Kuka, A.; Piazza, A.; Gaiarsa, S.; Merla, C.; Sottosanti, M.; Cambieri, P.; Migliavacca, R.; Baldanti, F. Enterobacter asburiae ST229: An emerging carbapenemases producer. Sci. Rep. 2024, 14, 6220. [Google Scholar] [CrossRef]
- IDSA 2024 Guidance on the Treatment of Antimicrobial Resistant Gram-Negative Infections. Available online: https://www.idsociety.org/practice-guideline/amr-guidance/#NotableUpdatesfromthe2023IDSAAMRGuidanceDocument (accessed on 24 August 2024).
- AlQahtani, H.; Baloch, S.; Aleanizy, F.S.; Alqahtani, F.Y.; Tabb, D. Influence of the minimum inhibitory concentration of daptomycin on the outcomes of Staphylococcus aureus bacteraemia. J. Glob. Antimicrob. Resist. 2021, 24, 23–26. [Google Scholar] [CrossRef]
- Zhang, F.; Liu, F.; Sheng, X.; Liu, Q.; Cui, L.; Cao, Z.; Hu, T.; Li, D.; Dai, M. Bacitracin-resistant Staphylococcus aureus induced in chicken gut and in vitro under bacitracin exposure. Microb. Pathog. 2024, 191, 106666. [Google Scholar] [CrossRef]
- Diederen, B.M.; van Duijn, I.; Willemse, P.; Kluytmans, J.A. In vitro activity of daptomycin against methicillin-resistant Staphylococcus aureus, including heterogeneously glycopeptide-resistant strains. Antimicrob Agents Chemother. 2006, 50, 3189–3191. [Google Scholar] [CrossRef] [PubMed]
- Kotey, F.C.; Dayie, N.T.; Tetteh-Uarcoo, P.B.; Donkor, E.S. Candida Bloodstream Infections: Changes in Epidemiology and Increase in Drug Resistance. Infect. Dis. 2021, 14, 11786337211026927. [Google Scholar] [CrossRef] [PubMed]
- Cook, A.; Ferreras-Antolin, L.; Adhisivam, B.; Ballot, D.; Berkley, J.A.; Bernaschi, P.; Carvalheiro, C.G.; Chaikittisuk, N.; Chen, Y.; Chibabhai, V.; et al. Neonatal invasive candidiasis in low- and middle-income countries: Data from the NeoOBS study. Med. Mycol. 2023, 61, myad010. [Google Scholar] [CrossRef] [PubMed] [PubMed Central]
- Barber, C.M.; Fahrenkopf, M.P.; Dietze-Fiedler, M.L.; Nguyen, J.L.; Girotto, J.A. Cutaneous Aspergillus fumigatus infection in a Newborn. Eplasty 2019, 19, ic13. [Google Scholar] [PubMed] [PubMed Central]
- Megri, Y.; Arastehfar, A.; Boekhout, T. Candida tropicalis is the most prevalent yeast species causing candidemia in Algeria: The urgent need for antifungal stewardship and infection control measures. Antimicrob. Resist. Infect. Control 2020, 9, 50. [Google Scholar] [CrossRef] [PubMed]
- Wang, F.; Wang, Y.; He, J.; Cheng, Z.; Wu, S.; Wang, M.; Niu, T. Clinical Characteristics and Risk Factors for Mortality in Cryptococcal Meningitis: Evidence from a Cohort Study. Front. Neurol. 2022, 13, 779435. [Google Scholar] [CrossRef] [PubMed]
- Papon, N.; Goldman, G.H. Unraveling Caspofungin Resistance in Cryptococcus neoformans. mBio 2021, 12, 10–128. [Google Scholar] [CrossRef]
- McHale, T.C.; Akampurira, A.; Gerlach, E.S.; Mucunguzi, A.; Nicol, M.R.; Williams, D.A.; Nielsen, K.; Bicanic, T.; Fieberg, A.; Dai, B.; et al. 5-Flucytosine Longitudinal Antifungal Susceptibility Testing of Cryptococcus neoformans: A Substudy of the EnACT Trial Testing Oral Amphotericin. In Open Forum Infectious Diseases; Oxford University Press: Oxford, UK, 2023; Volume 10, p. ofad596. [Google Scholar] [CrossRef]
- Loyse, A.; Dromer, F.; Day, J.; Lortholary, O.; Harrison, T.S. Flucytosine and cryptococcosis: Time to urgently address the worldwide accessibility of a 50-year-old antifungal. J. Antimicrob. Chemother. 2013, 68, 2435–2444. [Google Scholar] [CrossRef]
- Zhang, Q.; Beyi, A.F.; Yin, Y. Zoonotic and antibiotic-resistant Campylobacter: A view through the One Health lens. One Health Adv. 2023, 1, 4. [Google Scholar] [CrossRef]
- Jin, M.; Osman, M.; Green, B.A.; Yang, Y.; Ahuja, A.; Lu, Z.; Cazer, C.L. Evidence for the transmission of antimicrobial resistant bacteria between humans and companion animals: A scoping review. One Health 2023, 17, 100593. [Google Scholar] [CrossRef] [PubMed] [PubMed Central]
- Woerde, D.J.; Reagan, K.L.; Byrne, B.A.; Weimer, B.C.; Epstein, S.E.; Schlesener, C.; Huang, B.C.; Sykes, J.E. Characteristics of Extended-Spectrum β-Lactamase Producing Enterobacterales Isolated from Dogs and Cats, 2011–2021. Vet. Sci. 2023, 10, 178. [Google Scholar] [CrossRef]

| Target Gene | Primer Name | Primer Sequence | Expected Amplicon Size |
|---|---|---|---|
| 16 s rRNA | ITS_8F | AGGTTTGATCCTGGCTCAG | 1500 bp |
| ITS_U1492R | GGTTACCTTGTTACGACTT | ||
| ITS | ITS1-F | CTTGGTCATTTAGAGGAAGTAA | 600 bp |
| ITS4 | TCCTCCGCTTATTGATATGC | ||
| blaTEM | TEM-F | CATTTCCGTGTCGCCCTTATTC | 800 bp |
| TEM-R | CGTTCATCCATAGTTGCCTGAC | ||
| blaSHV | SHV-F | AGCCGCTTGAGCAAATTAAAC | 712 bp |
| SHV-R | ATCCCGCAGATAAATCACCAC | ||
| blaCTX-M group 1 | CTXM1-F | TTAGGAAATGTGCCGCTGTA | 688 bp |
| CTXM1-R | CGATATCGTTGGTGGTACCAT | ||
| blaCTX-M group 2 | CTXM2-F | CGTTAACGGCACGATGAC | 404 bp |
| CTXM2-R | CGATATCGTTGGTGGTACCAT | ||
| blaAmpC | AMPC-F | CCCCGCTTATAGAGCAACAA | 631 bp |
| AMPC-R | TCAATGGTCGACTTCACACC |
| Drug Class | AG | G | C | Macrolide | Penicillin’s | Cephalosporins | MB | Carbapenems | Quinolones | PM | TM | SXT | TET | ||||||||
|---|---|---|---|---|---|---|---|---|---|---|---|---|---|---|---|---|---|---|---|---|---|
| Antibiotic | S | VA | C | E | AZM | AMP | AMC | CPD | CTX | CRO | ATM | MEM | DOR | IMP | LEV | CIP | CS | TM | SXT | DO | |
| Conc. (µg/disc) | 10 | 30 | 30 | 15 | 15 | 10 | 20:10 | 10 | 5 | 30 | 30 | 10 | 10 | 10 | 5 | 5 | 10 | 5 | 25 | 10 | |
| Bacterial Isolate | VRE | R | R A | - | R | R | R | R | - | - | - | - | R | R | R | R B | R B | - | R | R | R |
| MRSA | R | 17 | 12 | 22 c | 20 | R D | 10 | R | R | R | - | 16 | 15 | 27 | 30 E | 28 f | - | 12 G | 12 G | R f | |
| K. pneumoniae | R | - | R E | R | R | R | R H | 9 | 12 E | 13 f | R c | 32 I | 32 c | 23 f | R H | R f | 11 | R B | R L | R | |
| A. Baumannii | 13 | - | R | R | R | R | R | R | R | R | R | 20 B | 15 f | 27 | 20 J | 17 c | R | R | R | 12 | |
| P. aeruginosa | 9 | - | R | R | 12 | R | R | R | R | R | 10 K | 22 G | 23 f | 25 | 20 K | 22 D | 10 | R | R | R | |
| E. asburiae | 17 | - | 15 E | R | 12 | R | 12 H | 26 | 29 E | 29 | 35 c | 27 I | 18 c | 26 f | 30 H | 32 f | 12 | 12 B | 17 L | 18 | |
| E. coli | 11 | - | R E | R | 11 | R | R H | R | R E | R | 14 c | 26I | 25 c | 28 f | 9 H | 14 f | 10 | R B | R L | 9 | |
| Antimicrobial | Bacterial Isolate | |||||||
|---|---|---|---|---|---|---|---|---|
| VRE | MRSA | K. pneumoniae | A. Baumannii | P. aeruginosa | E. asburiae | E. coli | ||
| Agent | Strip Range (µg/mL) | MIC (µg/mL) | ||||||
| Macrolides | ||||||||
| Erythromycin (E) | 0.016–256 | R | 1 B | R | R | R | R | R |
| Azithromycin (AZM) | 0.016–256 | R | 2 E | R | R | R | R | 48 |
| Glycopeptide | ||||||||
| Vancomycin (VA) | 0.016–256 | R A | 3 E | - | - | - | - | - |
| Dalbavancin (DAL) | 0.002–32 | 0.5 | 1 f | - | - | - | - | - |
| Streptogramin | ||||||||
| Quinupristin/dalfopristin (QDA) | 0.002–32 | R | 1.5 B | - | - | - | - | - |
| Penicillins | ||||||||
| Amoxicillin (AML) | 0.016–256 | R c | R | R c | R | R | R c | R c |
| Amoxicillin-clavulanic acid (2 µg/mL) (AMC) | 0.016/2–256/2 | R c | 8 | R c | R | R | 3 c | 16 c |
| Piperacillin (PIP) | 0.016–256 | R | R | R c | R | R H | R c | R c |
| Piperacillin-tazobactam (4 µg/mL) (TZP) | 0.016/4–256/4 | R | R | 16 c | 64 | 16 H | 2 c | 3 c |
| Cephalosporins | ||||||||
| Cefixime (CFM) | 0.016–256 | - | R | 16 B | 16 | R | R B | R B |
| Ceftazidime (CAZ) | 0.016–256 | - | 128 | 8 A | R | 12 c | 0.047 A | 6 A |
| Ceftriaxone (CRO) | 0.016–256 | - | 128 | 8 E | R | R | 0.125 | R E |
| Cefepime (FEP) | 0.002–32 | - | 96 | 2 A | R | 4 c | 0.047 | R A |
| Cefiderocol (FDC) | 0.016–256 | - | R | 1.5 E | R | 2 E | 0.016 | 0.094 E |
| Carbapenems | ||||||||
| Doripenem (DOR) | 0.002–32 | R | 3 | 0.094 E | 1.5 E | 1 E | 0.125 E | 0.012 E |
| Meropenem (MEM) | 0.002–32 | R | 3 | 1 c | 0.25 A | 0.19 c | 0.064 c | 0.047 c |
| Monobactams | ||||||||
| Aztreonam (ATM) | 0.016–256 | - | - | R A | R | 24 H | 0.19 A | 8 A |
| Aztreonam-Avibactam (AZA) | 0.016/4–256/4 | - | - | R | 64 | 3 | 0.023 | 0.125 |
| Fluoroquinolones | ||||||||
| Ciprofloxacin (CIP) | 0.002–32 | R A | 0.19 E | R G | 0.5 B | 0.125 G | 0.023 G | 3 G |
| Aminoglycosides | ||||||||
| Gentamicin (CN) | 0.016–256 | R D | 0.38 E | 1.5 E | 0.25 A | 3 | 3 E | R E |
| Tetracyclines | ||||||||
| Doxycycline (DXT) | 0.016–256 | R | 16 B | 64 G | 2 | R | 4 G | 24 G |
| Miscellaneous Agents | ||||||||
| Colistin (CS) | 0.016–256 | - | - | 8 E | 32 E | 6 A | 4 E | 4 E |
| Chloramphenicol (C) | 0.016–256 | - | 48 | R | R | R | 8 A | R A |
| Trimethoprim (TM) | 0.002–32 | R | 6 A | R A | R | R | R A | R A |
| Trimethoprim-sulfamethoxazole (1:19) (SXT) | 0.002–32 | R | 1 A | R A | R A | R | 0.25 | R |
| Antimicrobial Peptides | ||||||||
| Bacitracin (BA) | 0.016–256 | R | 12 | R | R | R | R | R |
| Daptomycin (DAP) | 0.016–256 | 2 | 4 | R | R | R | R | R |
| Drug Class. | Polyenes | Azoles | Antimetabolite | |
|---|---|---|---|---|
| Antifungal | AMP B | Fluconazole | Flucytosine | |
| Concentration (µg/disc) | 20 | 100 | 1 | |
| Fungal Isolate | C. albicans | 15 | R | R |
| C. glabrata | 10 | R | R | |
| C. krusei | R | R | R | |
| C. parapsilosis | 13 | 30 | R | |
| C. neoformans | 14 | 30 | R | |
| Antifungal | C. albicans | C. glabrata | C. krusei | C. parapsilosis | C. neoformans | |
|---|---|---|---|---|---|---|
| Test Agent | Strip Range MIC (µg/mL) | MIC (µg/mL) | ||||
| Polyenes | ||||||
| AMP B | 0.002–32 | 0.19 A | 0.125 A | 0.19 A | R A | 0.75 A |
| Azoles | ||||||
| Fluconazole | 0.016–256 | R B | R c | - | 3 B | 6 B |
| Echinocandins | ||||||
| Caspofungin | 0.002–32 | 0.38 | 0.5 | R | R | - |
| Antimetabolite | ||||||
| Flucytosine | 0.002–32 | R | R | R | R | R |
| Antimicrobial Peptides | ||||||
| Bacitracin | 0.016–256 | R | R | R | R | R |
| Daptomycin | 0.016–256 | R | R | R | R | R |
Disclaimer/Publisher’s Note: The statements, opinions and data contained in all publications are solely those of the individual author(s) and contributor(s) and not of MDPI and/or the editor(s). MDPI and/or the editor(s) disclaim responsibility for any injury to people or property resulting from any ideas, methods, instructions or products referred to in the content. |
© 2024 by the authors. Licensee MDPI, Basel, Switzerland. This article is an open access article distributed under the terms and conditions of the Creative Commons Attribution (CC BY) license (https://creativecommons.org/licenses/by/4.0/).
Share and Cite
Meade, E.; Slattery, M.A.; Garvey, M. Antimicrobial Resistance Profile of Zoonotic Clinically Relevant WHO Priority Pathogens. Pathogens 2024, 13, 1006. https://doi.org/10.3390/pathogens13111006
Meade E, Slattery MA, Garvey M. Antimicrobial Resistance Profile of Zoonotic Clinically Relevant WHO Priority Pathogens. Pathogens. 2024; 13(11):1006. https://doi.org/10.3390/pathogens13111006
Chicago/Turabian StyleMeade, Elaine, Mark Anthony Slattery, and Mary Garvey. 2024. "Antimicrobial Resistance Profile of Zoonotic Clinically Relevant WHO Priority Pathogens" Pathogens 13, no. 11: 1006. https://doi.org/10.3390/pathogens13111006
APA StyleMeade, E., Slattery, M. A., & Garvey, M. (2024). Antimicrobial Resistance Profile of Zoonotic Clinically Relevant WHO Priority Pathogens. Pathogens, 13(11), 1006. https://doi.org/10.3390/pathogens13111006

